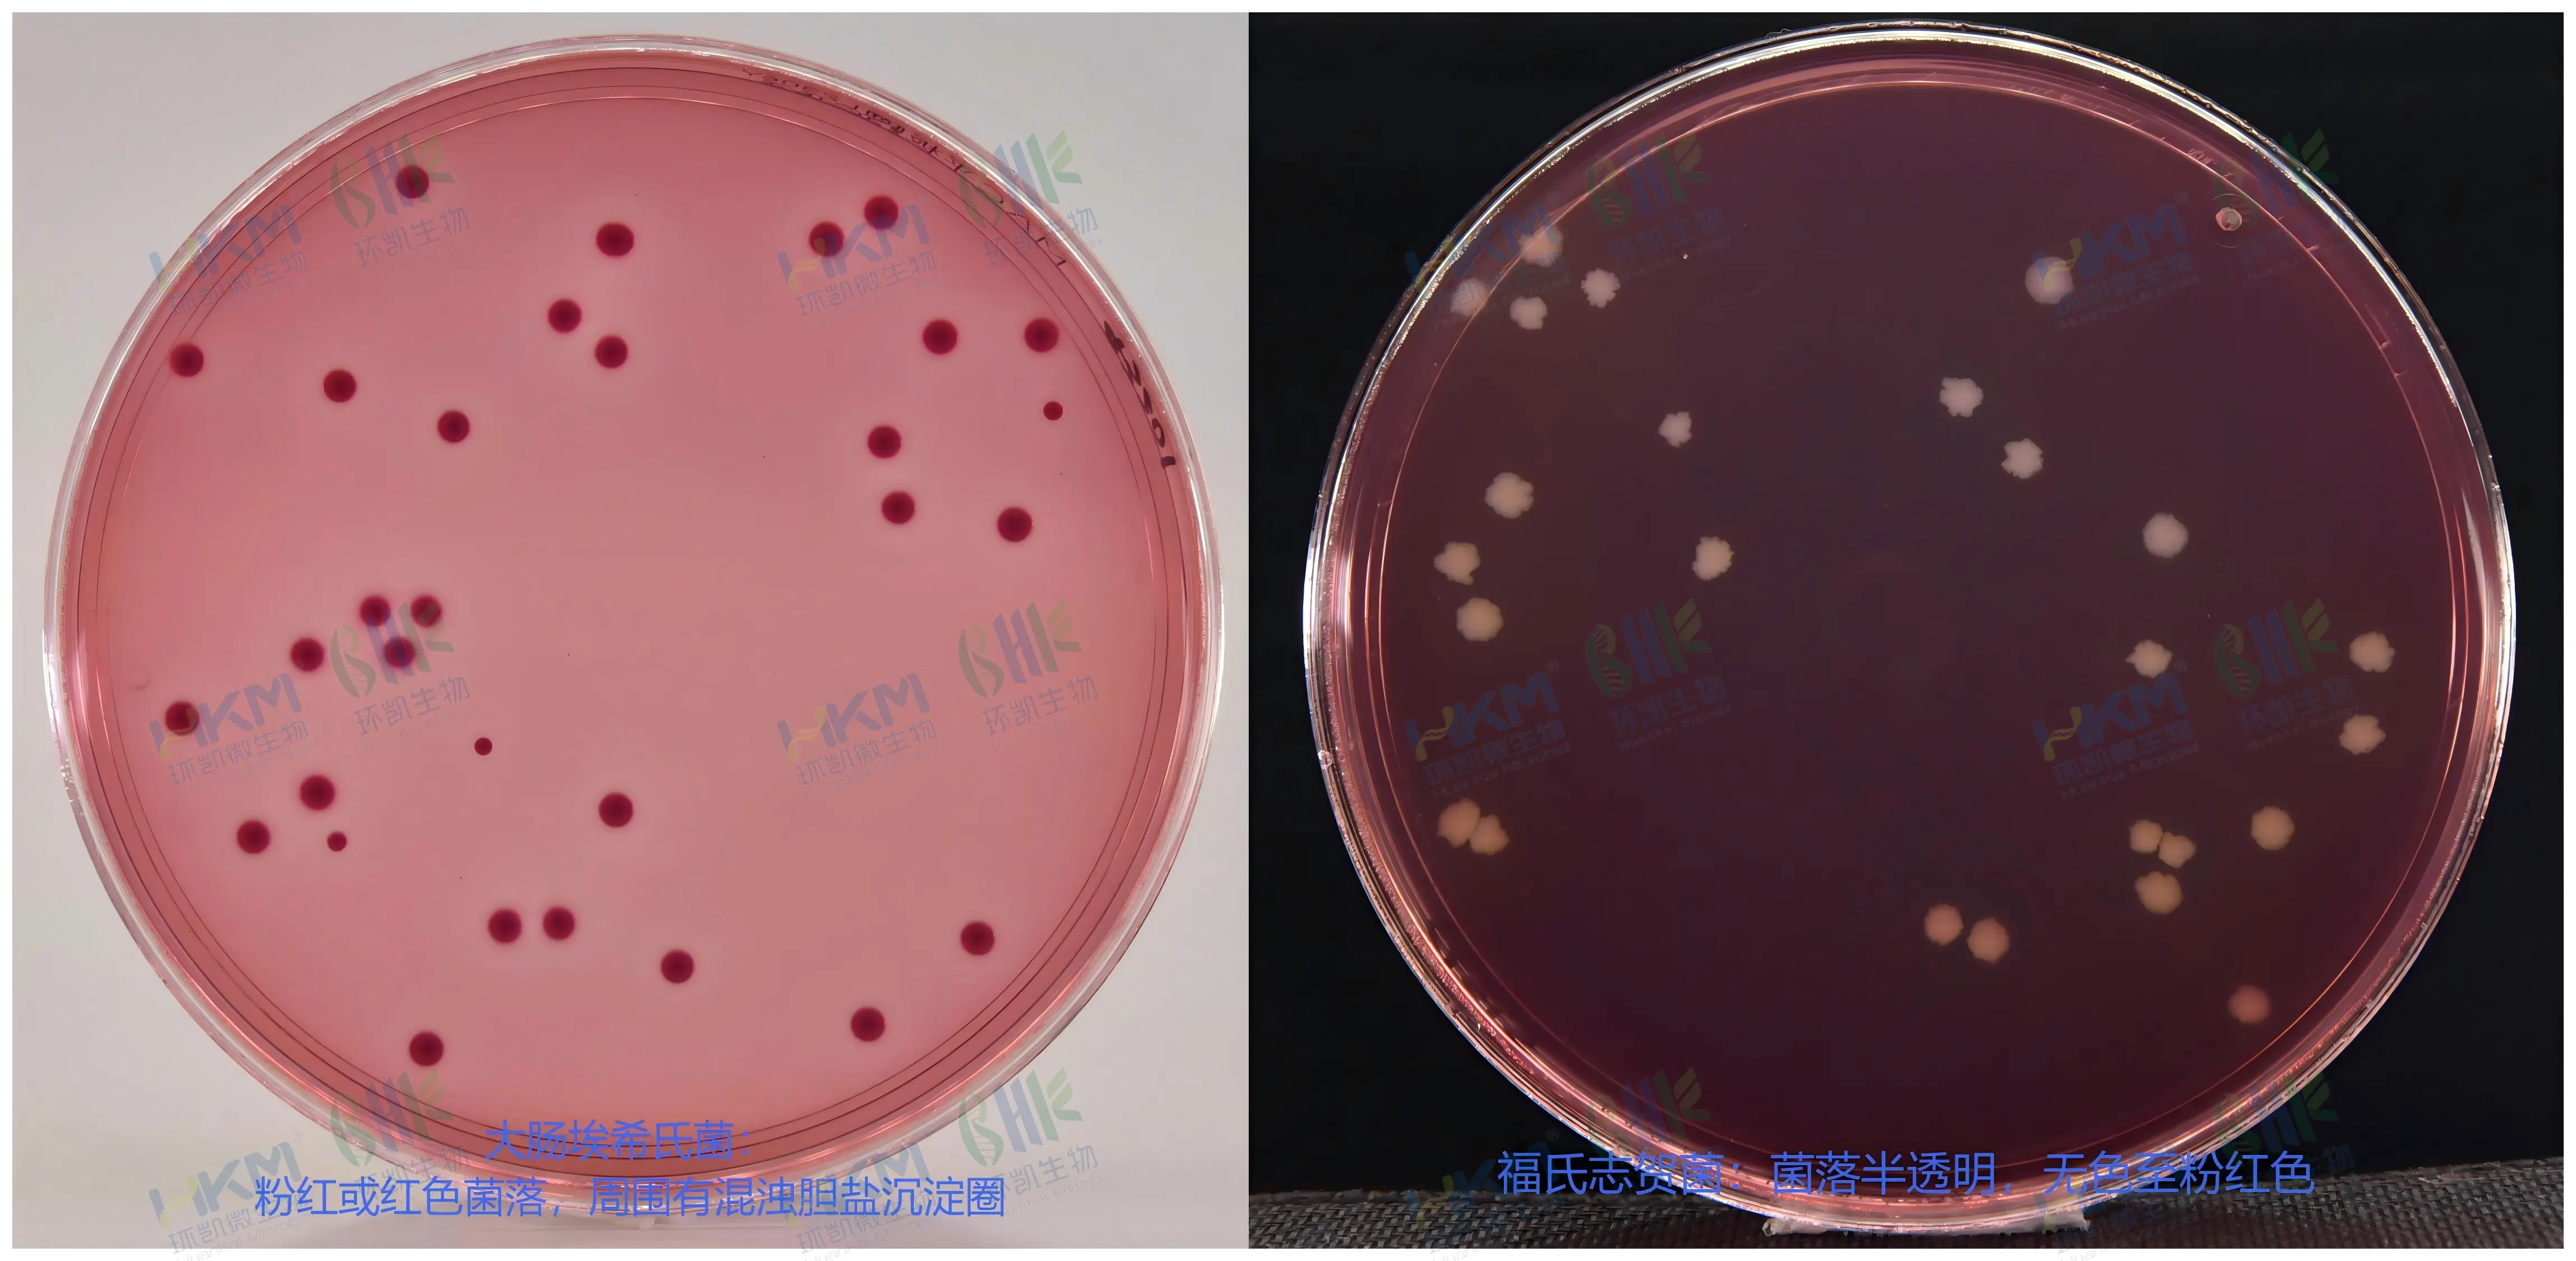
MAC平板培养基(麦康凯琼脂)(YYT1169)质量控制

商品详细
说明书
微生物图册
行业应用
相关论文
产品名称:麦康凯琼脂培养基(平板)
英文名称:Macconkey Agar Plate
其它叫法:MCA琼脂平板培养基
产品编号与包装规格:
| 产品编号 | 产品类型 | 包装规格 |
|---|---|---|
| 024076 | 即用型成品平板 | 90mm×20个/盒 |
用途:供分离发酵乳糖的革兰氏阴性肠道杆菌。
检验原理:蛋白胨、胨提供碳氮源、维生素和生长因子;牛胆盐和结晶紫可抑制革兰氏阳性菌的生长;氯化钠维持均衡的渗透压;琼脂是培养基的凝固剂;乳糖为可发酵的糖类;中性红是pH指示剂,细菌发酵乳糖产酸时菌落呈粉红色并在菌落周围出现胆盐沉淀的浑浊圈。
MAC平板培养基(麦康凯琼脂)配方成分:
| 配方 | 含量(每升) |
|---|---|
| 胨(蛋白胨) | 20.0g |
| 胆盐(牛胆盐) | 5.0g |
| 氯化钠 | 5.0g |
| 琼脂 | 14.0g |
| 乳糖 | 10.0g |
| 中性红 | 0.03g |
| 纯化水/蒸馏水 | 1000mL |
| 最终pH 7.2±0.2 | |
使用方法:洁净环境下拆包即可使用。
MAC平板培养基(麦康凯琼脂)质量控制(下列质控菌株接种待测试培养基,35~37℃,24h结果如下:)
| 指标 | 质控菌株及编号 | 标准值 | 特征性反应 |
|---|---|---|---|
| 生长率 | 大肠埃希氏菌ATCC25922 | PR≥0.5 | 粉红或红色菌落,周围有混浊胆盐沉淀圈 |
| 福氏志贺菌 CMCC(B)51572 | 菌落半透明,无色至粉红色 | ||
| 鼠伤寒沙门氏菌ATCC14028 | 菌落半透明,无色至粉红色 | ||
| 奇异变形杆菌CMCC(B)49005 | 菌落半透明,无色至粉红色 | ||
| 选择性 | 金黄色葡萄球菌ATCC6538 | G≤1 | — |
存储条件与保质期:2-25℃避光储存,保质期见产品标签。
参考文献:
1、《中华人民共和国药典》2010年版
2、YYT1169-2009 麦康凯琼脂培养基
MAC平板培养基(麦康凯琼脂)(YYT1169) 相关产品(用于大肠菌群、粪大肠菌群、大肠埃希氏菌检验培养基):
| 产品名称 | 产品货号 | 规格 | 产品说明及用途 |
|---|---|---|---|
| 品红亚硫酸钠培养基(远藤琼脂培养基) Endo Agar | 022150 | 250g | 用于水中大肠菌群的分离或确证试验。(GB) |
| MFC培养基 MFC Agar | 028950 | 250g | 用于水或其它样品中粪大肠菌群的滤膜法测定。(GB、SN) |
| 去氧胆酸盐琼脂 Desoxycholate Agar | 028130 | 250g | 用于革兰氏阴性肠道菌的选择性分离和平板计数。 |
| 十七烷基硫酸钠乳糖TTC(Tergitol-7)琼脂基础 Lactose TTC Agar with Sodium Heptadecyl Sulfate Base | 028951 | 250g | 添加配套试剂SR0540制成十七烷基硫酸钠乳糖TTC (Tergitol-7)琼脂,用于滤膜法检测水中大肠杆菌和大肠菌群。(IS09038-1-2000) |
| EC-MUG培养基 EC-MUG Medium | 028266 | 100g | 用于多管发酵法测定生活饮用水及其水源水中大肠埃希氏菌。(GB) |
| MMO-MUG培养基 MMO-MUG Medium | 028268 | 250g | 用于酶底物法测定水中总大肠菌群、粪大肠菌群和大肠埃希氏菌。(GB、HJ) |
| MUG营养琼脂培养基 NA-MUG Medium | 028267 | 100g | 用于滤膜法测定生活饮用水及其水源水中大肠埃希氏菌。(GB) |
| LES Endo琼脂 LES Endo Agar | 022151 | 250g | 用于滤膜法测定水中的大肠菌群。(GB) |
| mTEC琼脂 mTEC Agar | 028952 | 250g | 用于滤膜法测定水中的耐热大肠菌群。 |
| 大肠菌群显色培养基 Chromogenic ColiformAgar | CRM001 | 1000mL | 24h平板法快速检测大肠菌群。 |
| 大肠杆菌显色培养基 Chromogenic E.coil Agar | CRM002 | 1000mL | 24h平板法快速检测大肠杆菌。 |
| 大肠菌群大肠杆菌(ECC)显色培养基 Chromogenic Coliform & E.coil Agar | CRM003 | 1000mL | 24h平板法快速检测大肠菌群和大肠杆菌。 |
| 麦康凯肌醇阿东醇羧苄青霉素琼脂(MIAC) MacConkey Inositol Adonitol Carbenicillin Agar | 022147 | 250g | 用于肺炎克雷伯菌氏菌的分离与检测SN/T2552.9-2010 |
| Koser氏枸橼酸盐肉汤 Koser Citrate Medium | 022121 | 100g | 用于鉴定埃希氏菌属。(GB、 SN、美国FDA) |
| 麦康凯液体培养基 MacConkey Broth | 022039 | 250g | 用于药品中大肠埃希氏菌的选择性增菌培养。(ChP、EP、USP) |
| 肠道菌增菌液体培养基 Enterobacteriaceae Enrichment Broth(-Mossel) | 022161 | 250g | 用于耐胆盐革兰氏阴性菌的增菌培养。(ChP、 EP、 USP) |
| 麦康凯琼脂 MacConkey Agar | 022143 | 250g | 用于药品中大肠埃希氏菌的选择性分离培养。(ChP、EP、USP) |
| 紫红胆盐葡萄糖琼脂培养基 Violet Red Bile Glucose Agar | 022223 | 250g | 用于耐胆盐革兰氏阴性菌的选择性分离培养。(ChP、EP、USP) |
| 胆盐乳糖培养基(BL) Bile Lactose Broth | 022170 | 250g | 用于大肠杆菌和绿脓杆菌的增菌培养用。(CP) |
| 曙红亚甲基蓝琼脂培养基(EMB) Eosin Methlene Blue Agar II | 022141 | 250g | 用于大肠杆菌、大肠菌群的分离。(ChP) |
| 4-甲基伞形酮糖苷酸培养基(MUG培养基) MUGmedium | 028265 | 100g | 用于大肠埃希氏菌的快速测定,可观察荧光和吲哚试验。(ChP) |
| 月桂基硫酸盐胰蛋白胨肉汤(LST) Lauryl Sulfate Tryptose Broth | 022210 | 250g | 用于多管发酵法测定大肠菌群和粪大肠菌群。(GB、SN、美国FDA、ISO) |
| EC肉汤 EC Medium | 022230 | 250g | 用于多管发酵法测定粪大肠菌群和大肠杆菌的确证试验。(GB、SN、美国FDA、ISO) |
| 煌绿乳糖胆盐肉汤(BGLB) Brilliant Green Lactose Bile Broth | 022220 | 250g | 用于多管发酵法测定大肠菌群的确证试验。(GB、 SN、 美国FDA、ISO) |
| 乳糖胆盐发酵培养基 Lactose Bile Ferment Broth | 022040 | 250g | 用于多管发酵法测定食品、饮用矿泉水和一次性使用卫生用品中大肠菌群、粪大肠菌群和大肠杆菌。(GB) |
| 乳糖胆盐培养基(不含中和剂) Lactose Bile Broth | 022041 | 250g | 用于化妆品粪大肠菌群的测定。(化妆品卫生规范1987版) |
| 双倍乳糖胆盐(含中和剂)培养基 Double Lactose Bile Broth | 022043 | 250g | 用于化妆品粪大肠菌群的测定。(化妆品卫生规范2015版) |
| 乳糖发酵培养基(乳糖复发酵培养基) L actose Ferment Broth | 022050 | 250g | 用于多管发酵法测定一次性使用卫生用品中大肠菌群的确证试验。(GB) |
| 肠道菌增菌肉汤(EE) Enterobacteriaceae Enrichment Broth(-Mossel) (Buffered brilliant green bile glucose broth) | 022160 | 250g | 用于肠道菌增菌(GB、 ISO、EP、USP),特别用于阪崎肠杆菌的选择性增菌培养。(SN、美国FDA)(GB) |
| 乳糖蛋白胨培养液 Lactose Peptone Broth | 022200 | 250g | 用于水中多管发酵法或滤膜法测定大肠菌群。(GB) |
| 亮绿乳糖胆盐培养基(BGLB) Brilliant Green Bile Broth | 022190 | 250g | 用于水中多管发酵法测定饮用矿泉水中大肠菌群的确证试验。(GB) |
| 结晶紫中性红胆盐琼脂(VRBA) Violet Red Bile Agar | 022221 | 250g | 用于水或食品中大肠菌群平板菌落计数。(GB、 SN、美国FDA) |
| 伊红美蓝琼脂培养基(EMB) Eosin Methlene Bule Agar | 022060 | 250g | 用于分离革兰氏阴性肠道菌特别是大肠菌群和粪大肠菌群。(GB、SN、美国FDA) |
| 结晶紫中性红胆盐MUG琼脂 VRB-MUG Agar | 022225 | 100g | 用于食品中大肠杆菌的平板计数。(GB、 美国FDA) |
本产品仅限于科研研究用途,不能用于医院和临床检测,购买者请知悉!
